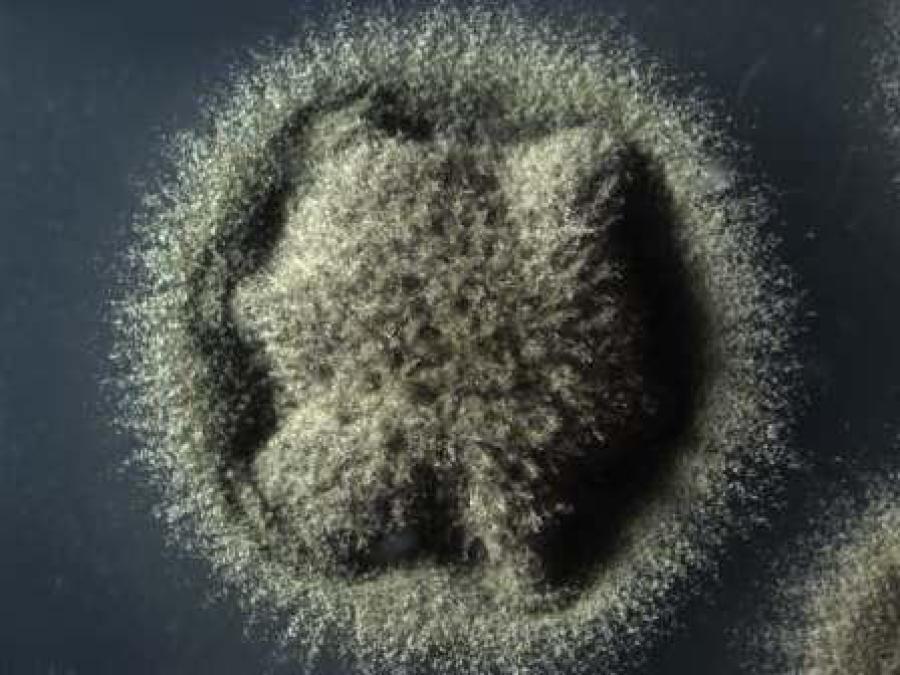

Cladosporium
Cladosporium ist eine Gattung der Schimmelpilze und umfasst derzeit 263 Arten mit kosmopolitischer Verbreitung.
In Innenräumen treten Cladosporium-Arten als häufige Wandschimmel auf.
Die meisten Cladosporium-Arten wachsen bei sehr hoher Wasseraktivität (>0,85). Daher kann man einen Befall mit Cladosporium häufig in Badezimmern, in Silikonfugen, an Fensterrahmen etc. finden.
Cladosporium-Arten können Mykotoxine bilden.
Die Konidien von Cladosporium können bei sensibilisierten Menschen Allergien erzeugen.
Opportunistische Erkrankungen werden durch Cladosporium-Arten äußerst selten hervorgerufen.
Die systematische Einordnung von Cladosporium erfolgt bei den Ascomycota, Klasse Dothideomycetes, Ordnung, Capnodiales, Familie Cladosporiaceae.
Cladosporium-Arten:
- Cladosporium acaciicola M.B. Ellis, 1976
- Cladosporium acalyphae Bensch, H.D. Shin, Crous & U. Braun, 2010
- Cladosporium adianticola R.F. Castañeda, 1987
- Cladosporium aecidiicola Thüm., 1876
- Cladosporium agoseridis U. Braun & Rogerson, 1995
- Cladosporium albiziae S.N. Khan & B.M. Misra, 1999
- Cladosporium algarum Cooke & Massee, 1888
- Cladosporium allicinum (Fr.) Bensch, U. Braun & Crous, 2012
- Cladosporium allii (Ellis & G. Martin) P.M. Kirk & J.G. Crompton, 1984
- Cladosporium allii-cepae (Ranoj.) M.B. Ellis, 1976
- Cladosporium allii-porri (Sacc. & Briard) Boerema, 1978
- Cladosporium alliicola H.D. Shin & U. Braun, 1995
- Cladosporium alneum Pass. ex K. Schub., 2006
- Cladosporium alopecuri (Ellis & Everh.) U. Braun, 2000
- Cladosporium alternicoloratum R.F. Castañeda & W.B. Kendr., 1991
- Cladosporium angustisporum Bensch, Summerell, Crous & U. Braun, 2010
- Cladosporium antarcticum K. Schub., Crous & U. Braun, 2007
- Cladosporium antillanum R.F. Castañeda, 1987
- Cladosporium aphidis Thüm., 1877
- Cladosporium apicale Berk. & Broome, 1873
- Cladosporium aristolochiae H. Zhang & Z.Y. Zhang, 1998
- Cladosporium aromaticum Ellis & Everh., 1895
- Cladosporium arthoniae M.S. Christ. & D. Hawksw., 1979
- Cladosporium arthrinioides Thüm. & Beltrani, 1876
- Cladosporium arthropodii K. Schub. & C.F. Hill, 2006
- Cladosporium asperistipitatum U. Braun & K. Schub., 2007
- Cladosporium asperulatum Bensch, Crous & U. Braun, 2010
- Cladosporium astroideum Ces., 1853
- Cladosporium atriellum Cooke, 1878
- Cladosporium atroseptum Pidopl., 1953
- Cladosporium auriculae (Cooke) J.C. David, 1997
- Cladosporium australiense Bensch, Summerell, Crous & U. Braun, 2010
- Cladosporium baccae Verwoerd & Dippen., 1930
- Cladosporium balladynae Deighton, 1969
- Cladosporium banaticum Savul., 1951
- Cladosporium basi-inflatum Bensch, Crous & U. Braun, 2010
- Cladosporium bauhiniana Arv. Kumar, Anuj Kumar & Kharwar, 2006
- Cladosporium boenninghauseniae Togashi & Katsuki, 1951
- Cladosporium borassi Hasija, 1967
- Cladosporium bosciae (Sacc.) K. Schub., 2006
- Cladosporium brachormium Berk. & Broome, 1850
- Cladosporium brassicae (Ellis & Barthol.) M.B. Ellis, 1976
- Cladosporium brassicicola Sawada, 1959
- Cladosporium brevicatenulatum Rebrik. & Sizova, 1978
- Cladosporium brevipes Peck, 1887
- Cladosporium breviramosum Morgan-Jones, 1988
- Cladosporium brunneoatrum McAlpine, 1899
- Cladosporium brunneolum Sacc., 1886
- Cladosporium brunneum Corda, 1837
- Cladosporium buchananiae S. Shrivast., N. Verma & A.N. Rai, 2010
- Cladosporium buteicola Cooke, 1876
- Cladosporium butyri C.N. Jensen, 1901
- Cladosporium caraganae K. Schub., U. Braun & H.D. Shin, 2007
- Cladosporium carpesii Sawada, 1958
- Cladosporium cassiae-surathensis J.M. Yen, 1981
- Cladosporium castellanii Borelli & Marcano, 1973
- Cladosporium chalastosporoides Bensch, Crous & U. Braun, 2010
- Cladosporium chamaeropis (Unamuno) K. Schub., 2006
- Cladosporium cheonis (Chupp & Linder) U. Braun, 2003
- Cladosporium chlamydeum Cif. & Redaelli, 1957
- Cladosporium chrysanthemi A.K. Das, 2003
- Cladosporium chrysophylli Thaung, 1974
- Cladosporium chubutense K. Schub., Gresl. & Crous, 2009
- Cladosporium circaea Y. Qin & Z.Y. Zhang, 1999
- Cladosporium citri Massee, 1899
- Cladosporium cladosporioides (Fresen.) G.A. de Vries, 1952
- Cladosporium colocasiae Sawada, 1916
- Cladosporium colocasiicola Sawada, 1959
- Cladosporium colombiae K. Schub. & Crous, 2009
- Cladosporium confusum Matsush., 1983
- Cladosporium coralloides W. Yamam. ex Dugan, K. Schub. & U. Braun, 2004
- Cladosporium coryphae (Syd. & P. Syd.) J.C. David, 1997
- Cladosporium cucumerinum Ellis & Arthur, 1889
- Cladosporium cycadacearum Sh. Kumar, Raghv. Singh, V.K. Pal, Upadhyaya & D.K. Agarwal, 2007
- Cladosporium cycadicola Crous & R.G. Shivas, 2014
- Cladosporium cyrtomii Z.Y. Zhang, H.H. Peng & H. Zhang, 1998
- Cladosporium desmodicola A.K. Das, 2003
- Cladosporium dianellicola Y. Cui & Z.Y. Zhang, 2001
- Cladosporium diaphanum Thüm., 1881
- Cladosporium digitalicola Z.Y. Zhang, T. Zhang & W.Q. Pu, 1998
- Cladosporium dominicanum Zalar, de Hoog & Gunde-Cim., 2007
- Cladosporium dracaenatum Thüm., 1881
- Cladosporium edgeworthiae H. Zhang & Z.Y. Zhang, 1998
- Cladosporium elegans Penz., 1882
- Cladosporium elsinoes H.C. Greene, 1959
- Cladosporium elymi (Rostr.) U. Braun, 2015
- Cladosporium epimyces Cooke, 1888
- Cladosporium epiphyllum (Pers.) Nees, 1816
- Cladosporium erianthi Thüm., 1879
- Cladosporium exasperatum Bensch, Summerell, Crous & U. Braun, 2010
- Cladosporium exile Bensch, Glawe, Crous & U. Braun, 2010
- Cladosporium exobasidii Jaap, 1907
- Cladosporium extorre Sacc., 1920
- Cladosporium ferox (Kabát & Bubák ex Lindau) J.C. David, 1997
- Cladosporium festucae Sawada, 1958
- Cladosporium flabelliforme Bensch, Summerell, Crous & U. Braun, 2010
- Cladosporium foliorum Ellis & Everh. ex K. Schub., 2006
- Cladosporium forsythiae Z.Y. Zhang & T. Zhang, 1999
- Cladosporium fraxinicola K. Schub. & Mulenko, 2006
- Cladosporium fuligineum Bonord., 1864
- Cladosporium fumagineum Sacc., 1920
- Cladosporium funiculosum W. Yamam., 1959
- Cladosporium fusiforme Zalar, de Hoog & Gunde-Cim., 2007
- Cladosporium galii Mulenko, K. Schub. & M. Kozlowska, 2004
- Cladosporium gallicola B. Sutton, 1973
- Cladosporium gamsianum Bensch, Crous & U. Braun, 2010
- Cladosporium geniculatum Morgan-Jones, 1988
- Cladosporium gerwasiae Heuchert, U. Braun & K. Schub., 2005
- Cladosporium globisporum Bensch, Crous & U. Braun, 2010
- Cladosporium glochidionis C.D. Sharma, Gadp., Firdousi, A.N. Rai & K.M. Vyas, 1998
- Cladosporium gossypiicola Pidopl. & Deniak, 1935
- Cladosporium grevilleae Crous & Summerell, 2011
- Cladosporium grumosum (Pers.) Link, 1824
- Cladosporium gynoxidicola Petr., 1948
- Cladosporium halotolerans Zalar, de Hoog & Gunde-Cim., 2007
- Cladosporium haplophylli (Vasyag. & Tartenova) J.C. David, 1997
- Cladosporium harknessii (Peck) S. Hughes, 1953
- Cladosporium heleophilum J.C. David, 1997
- Cladosporium helicosporum R.F. Castañeda & W.B. Kendr., 1997
- Cladosporium heliotropii Erikss., 1891
- Cladosporium herbaroides K. Schub., Zalar, Crous & U. Braun, 2007
- Cladosporium herbarum (Pers.) Link, 1816
- Cladosporium heterophragmatis S.A. Khan & M. Kamal, 1962
- Cladosporium heuglinianum Thüm., 1879
- Cladosporium hillianum Bensch, Crous & U. Braun, 2010
- Cladosporium hordei Pass., 1887
- Cladosporium humile Davis, 1919
- Cladosporium hydrangeae Z.Y. Zhang & T.F. Li, 1999
- Cladosporium indicum J.N. Rai, J.P. Tewari & Mukerji, 1969
- Cladosporium indigoferae Sawada, 1959
- Cladosporium inopinum (Petr.) U. Braun, 1995
- Cladosporium inversicolor Bensch, Crous & U. Braun, 2010
- Cladosporium iranicum Bensch, Crous & U. Braun, 2010
- Cladosporium iridis (Fautrey & Roum.) G.A. de Vries, 1952
- Cladosporium jacarandicola K. Schub., U. Braun & C.F. Hill, 2004
- Cladosporium juglandinum Cooke, 1888
- Cladosporium kapildharens C.D. Sharma, Gadp., Firdousi, A.N. Rai & K.M. Vyas, 1998
- Cladosporium lacroixii Desm., 1860
- Cladosporium ladinum E. Müll., 1950
- Cladosporium langeronii (Fonseca, Leão & Nogueira) Vuill., 1931
- Cladosporium laxicapitulatum Matsush., 1975
- Cladosporium leguminicola U. Braun & K. Schub., 2007
- Cladosporium leprosum Morgan-Jones, 1977
- Cladosporium licheniphilum Heuchert & U. Braun, 2006
- Cladosporium linicola Pidopl. & Deniak, 1953
- Cladosporium liriodendri K. Schub. & U. Braun, 2006
- Cladosporium lophodermii Georgescu & Tutunaru, 1958
- Cladosporium lupiniphilum U. Braun, 1998
- Cladosporium machili Sawada, 1959
- Cladosporium macrocarpum Preuss, 1848
- Cladosporium magnusianum (Jaap) M.B. Ellis, 1976
- Cladosporium malvacearum C.D. Sharma, Gadp., Firdousi, A.N. Rai & K.M. Vyas, 1998
- Cladosporium manoutchehrii Esfand., 1951
- Cladosporium melospermae K. Schub. & U. Braun, 2007
- Cladosporium metaplexis Z.Y. Zhang & Xue Y. Wang, 2000
- Cladosporium milii Syd., 1914
- Cladosporium mimulicola U. Braun, 1994
- Cladosporium minourae Iwatsu, 1984
- Cladosporium molle Cooke, 1878
- Cladosporium murorum Petr., 1942
- Cladosporium myriosporum Ellis & Dearn., 1897
- Cladosporium myrtacearum K. Schub., U. Braun & R.G. Shivas, 2005
- Cladosporium myrticola Bubák, 1915
- Cladosporium neocheiropteridis Yun L. Liu & Z.Y. Zhang, 2000
- Cladosporium neottopteridis Yun L. Liu & Yong H. He, 2000
- Cladosporium neriicola S.A. Khan & M. Kamal, 1974
- Cladosporium nigrelloides U. Braun & Mouch., 1999
- Cladosporium nigrellum Ellis & Everh., 1894
- Cladosporium nitrariae Dumitras & Bontea, 1967
- Cladosporium nodulosum Corda, 1837
- Cladosporium obtectum Rabenh., 1889
- Cladosporium oncobae K. Schub. & C.F. Hill, 2006
- Cladosporium orchidearum Cooke & Massee, 1888
- Cladosporium orchidiphilum K. Schub. & U. Braun, 2004
- Cladosporium orchidis E.A. Ellis & M.B. Ellis, 1972
- Cladosporium oreodaphnes Allesch. ex K. Schub., 2006
- Cladosporium ossifragi (Rostr.) U. Braun & K. Schub., 2007
- Cladosporium ovorum Pidopl. & Deniak, 1953
- Cladosporium oxysporum Berk. & M.A. Curtis, 1868
- Cladosporium pallidum Berk. & M.A. Curtis, 1860
- Cladosporium paracladosporioides Bensch, Crous & U. Braun, 2010
- Cladosporium perangustum Bensch, Crous & U. Braun, 2010
- Cladosporium pericarpium Cooke, 1883
- Cladosporium peruamazonicum Matsush., 1993
- Cladosporium pestalotiopsidis R.L. Zhao & G.C. Zhao, 2014
- Cladosporium phaenocomae Crous, 2011
- Cladosporium phlei (C.T. Greg.) G.A. de Vries, 1952
- Cladosporium phlei-pratensis Sawada, 1958
- Cladosporium phyllachorae M.B. Ellis, 1976
- Cladosporium phyllactiniicola Bensch, Glawe, Crous & U. Braun, 2010
- Cladosporium phyllogenum K. Schub., 2008
- Cladosporium phyllophilum McAlpine, 1896
- Cladosporium pini-ponderosae K. Schub., Gresl. & Crous, 2009
- Cladosporium pipericola R.A. Singh & Shankar, 1971
- Cladosporium pisi Cugini & Macch., 1891
- Cladosporium platycodonis Z.Y. Zhang & H. Zhang, 2000
- Cladosporium polygonati M.B. Ellis, 1976
- Cladosporium polymorphosporum R.F. Castañeda & W.B. Kendr., 1991
- Cladosporium populicola K. Schub. & U. Braun, 2006
- Cladosporium praecox (Niessl) U. Braun, 2000
- Cladosporium pseudiridis K. Schub., C.F. Hill, Crous & U. Braun, 2007
- Cladosporium pseudocladosporioides Bensch, Crous & U. Braun, 2010
- Cladosporium psidiicola J.M. Yen, 1980
- Cladosporium psoraleae M.B. Ellis, 1972
- Cladosporium psychrotolerans Zalar, de Hoog & Gunde-Cim., 2007
- Cladosporium pucciniae R.L. Zhao, 2014
- Cladosporium punctulatum Sacc. & Ellis, 1882
- Cladosporium ramotenellum K. Schub., Zalar, Crous & U. Braun, 2007
- Cladosporium ramulosum Reissek, 1851
- Cladosporium rectangulare K. Schub. & U. Braun, 2004
- Cladosporium rectoides Bensch, H.D. Shin, Crous & U. Braun, 2010
- Cladosporium rhododendri K. Schub., 2007
- Cladosporium robiniae (Kabát & Bubák) J.C. David, 1997
- Cladosporium rutae (T.M. Achundov) U. Braun, 1998
- Cladosporium salicis-sitchensis Dearn. & Barthol., 1924
- Cladosporium salinae Zalar, de Hoog & Gunde-Cim., 2007
- Cladosporium sarmentorum (Riedl & Ershad) U. Braun, 2009
- Cladosporium scabrellum Bensch, Schroers, Crous & U. Braun, 2010
- Cladosporium schizothytii R.L. Zhao & G.C. Zhao, 2012
- Cladosporium silenes Crous, 2011
- Cladosporium sinuosum K. Schub., C.F. Hill, Crous & U. Braun, 2007
- Cladosporium smilacicola K. Schub., 2006
- Cladosporium soldanellae Jaap, 1907
- Cladosporium sorghi S.R. Chowdhury, 1970
- Cladosporium sphaeroideum Cooke, 1879
- Cladosporium sphaerospermum Penz., 1882
- Cladosporium spinaciarum Raghv. Singh, Sh. Kumar, Pall. Sharma, K. Shukla, Kamal & D.K. Agarwal, 2008
- Cladosporium spinulosum Zalar, de Hoog & Gunde-Cim., 2007
- Cladosporium spongiosum Berk. & M.A. Curtis, 1868
- Cladosporium straminicola Pidopl. & Deniak, 1953
- Cladosporium strobilanthis H.J. Lu, Yun L. Liu & Z.Y. Zhang, 2003
- Cladosporium subinflatum K. Schub., Zalar, Crous & U. Braun, 2007
- Cladosporium subnodosum Cooke, 1877
- Cladosporium subobtectum U. Braun & K. Schub., 2007
- Cladosporium subsessile Ellis & Barthol., 1896
- Cladosporium subtilissimum K. Schub., Dugan, Crous & U. Braun, 2007
- Cladosporium subuliforme Bensch, Crous & U. Braun, 2010
- Cladosporium syringae (Oudem.) Montem., 1915
- Cladosporium syringicola K. Schub. & U. Braun, 2006
- Cladosporium telinicola G.C. Zhao & R.L. Zhao, 2014
- Cladosporium tenellum K. Schub., Zalar, Crous & U. Braun, 2007
- Cladosporium tenuissimum Cooke, 1878
- Cladosporium tetrapanacis D.X. Wu & Z.Y. Zhang, 2003
- Cladosporium trilliicola J.C. David, 2004
- Cladosporium typhae Schwein., 1832
- Cladosporium typharum Desm., 1834
- Cladosporium uniseptosporum Matsush., 1975
- Cladosporium uredinicola Speg., 1912
- Cladosporium uredinis Deighton, 1969
- Cladosporium variabile (Cooke) G.A. de Vries, 1952
- Cladosporium varians U. Braun, Melnik & K. Schub., 2008
- Cladosporium velox Zalar, de Hoog & Gunde-Cim., 2007
- Cladosporium velutinum Ellis & Tracy, 1890
- Cladosporium verrucocladosporioides Bensch, H.D. Shin, Crous & U. Braun, 2010
- Cladosporium verrucomycelium G.C. Zhao & R.L. Zhao, 2014
- Cladosporium victorialis (Thüm.) U. Braun & H.D. Shin, 1997
- Cladosporium vignae M.W. Gardner, 1925
- Cladosporium vincicola U. Braun & K. Schub., 2008
- Cladosporium xylophilum Bensch, Shabunin, Crous & U. Braun, 2010
- Cladosporium xyridis Tracy & Earle, 1896
- Cladosporium yuccae U. Braun, 2009
- Cladosporium zeae Peck, 1894
- Cladosporium ziziphi P. Karst. & Roum., 1890
Hinweis für Sachverständige: Obwohl Cladosporium-Arten zu den häufigsten Pilzen weltweit gehören und diese nahezu in jeder Außenluftprobe zu finden sind, bedeutet dies nicht, dass diese in Innenräumen unbedenklich wären. Cladosporium ist ein häufiger Bestandteil von Wandschimmel in Innenräumen mit vergleichsweise hohem allergenen Potential.